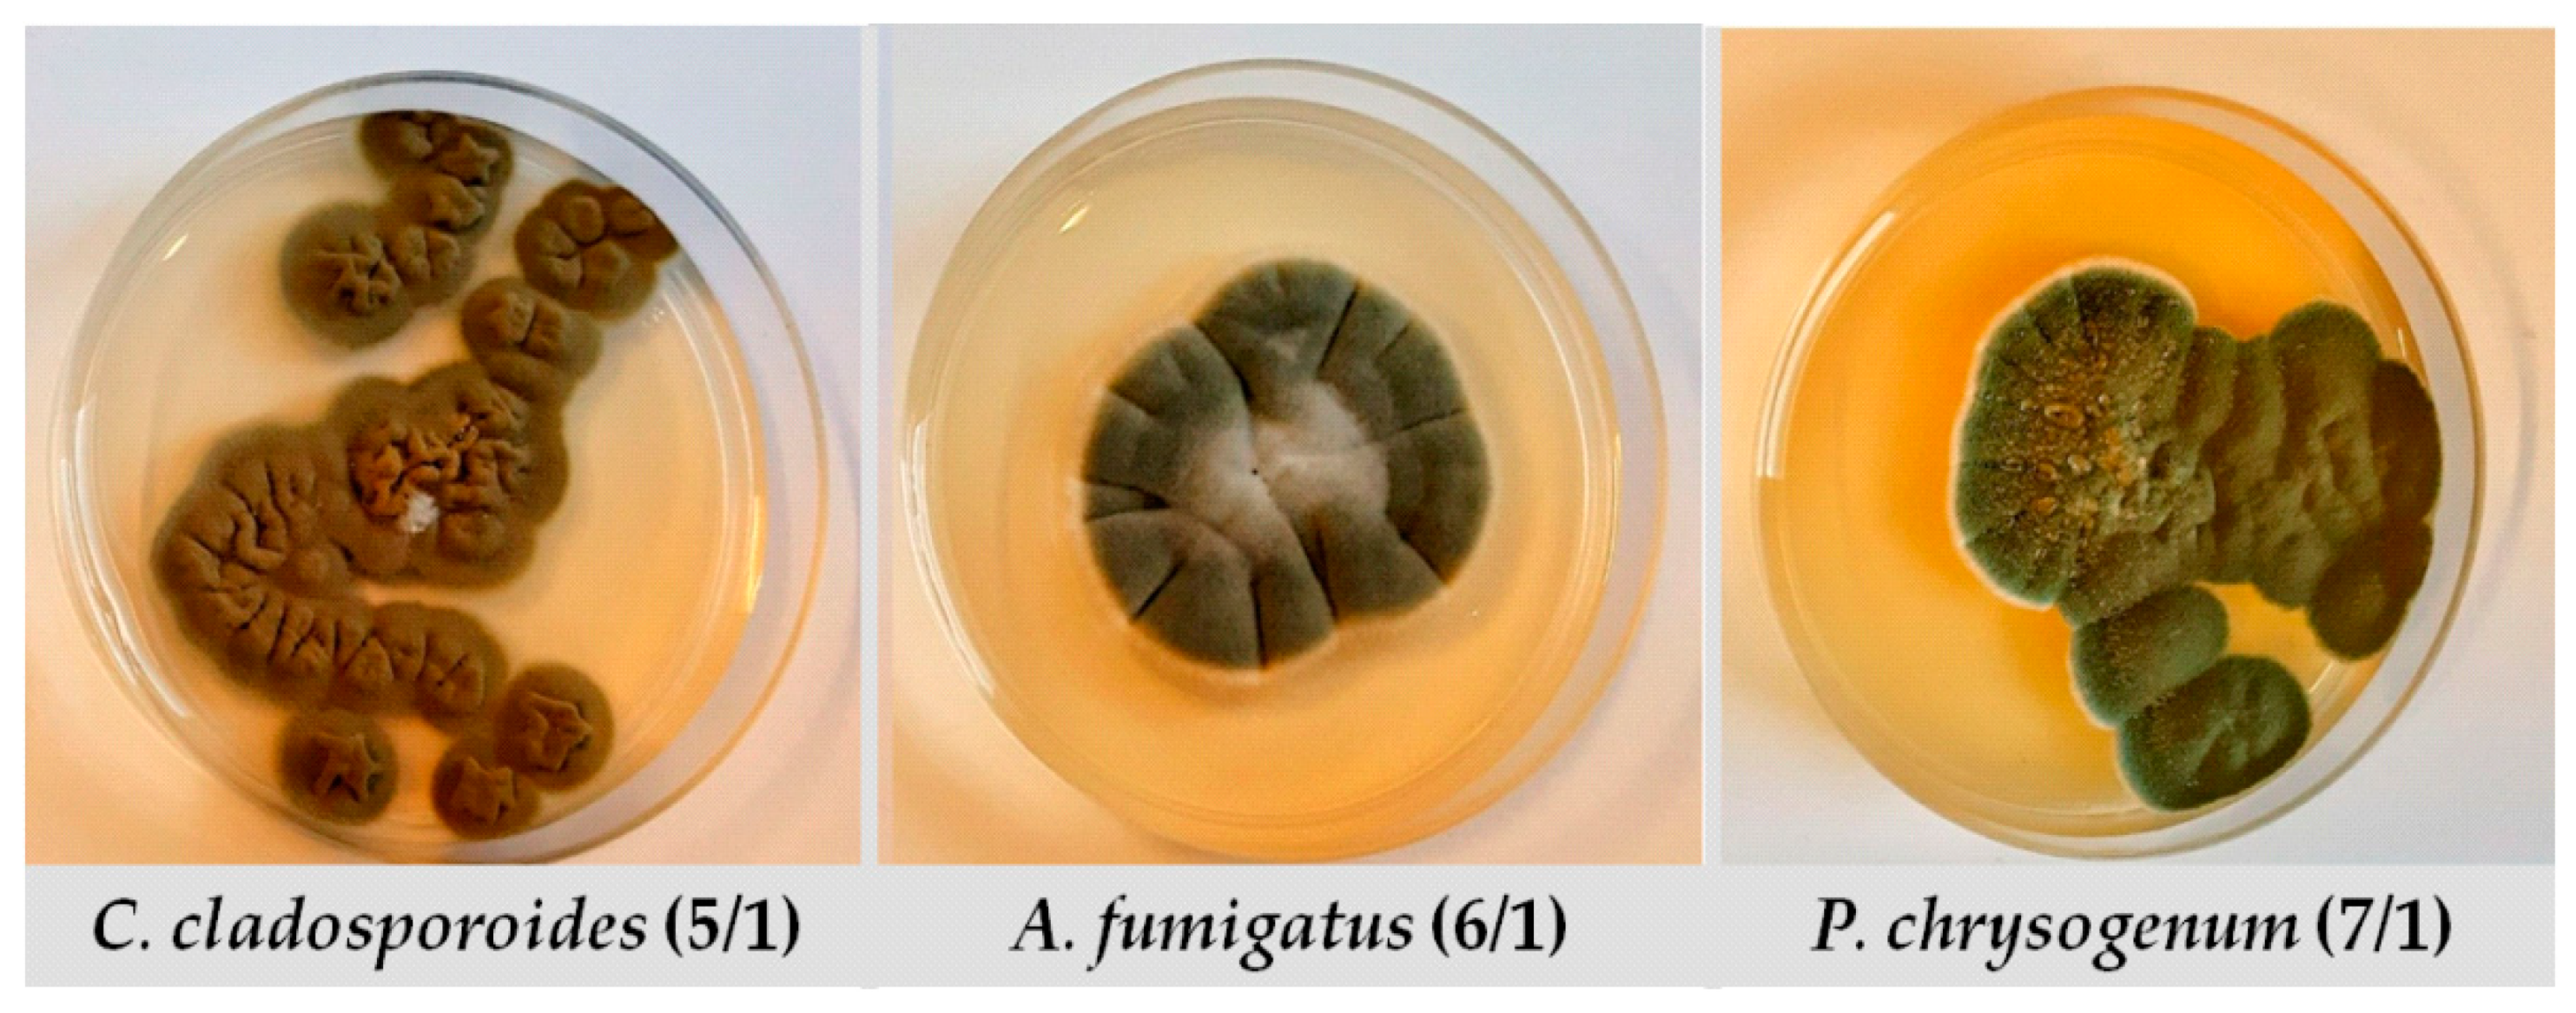
Antibiotics 12 00103 g003 Antibiotics 12 00103 g003

Screening of Antifungal Activity of Essential Oils in Controlling Biocontamination of Historical Papers in Archives
Abstract
1. Introduction
2. Results
2.1. Screening of the EOs’ Antifungal Activity
2.2. Minimal Inhibitory Concentration Determination
2.3. Time-Kill Kinetics Study
2.4. Chemical Composition of Selected EOs
2.5. EOs Efficiency in Vapour Phase
2.6. EOs In Situ Application onto Historical Paper Samples
3. Discussion
4. Materials and Methods
4.1. Tested Fungi
4.2. EOs
4.3. Screening of the EOs Antifungal Activity
4.4. MIC Determination
4.5. Time-Kill Kinetics Study
4.6. Chemical Composition of Selected EOs
4.7. EOs Efficiency in Vapour Phase
4.8. EOs In Situ Application onto Historical Paper Samples
5. Conclusions
Supplementary Materials
Author Contributions
Funding
Institutional Review Board Statement
Informed Consent Statement
Data Availability Statement
Acknowledgments
Conflicts of Interest
References
- Kozics, K.; Buckova, M.; Puskarova, A.; Kalaszova, V.; Cabicarova, T.; Pangallo, D. The effect of ten essential oils on several cutaneous drug-resistant microorganisms and their cyto/genotoxic and antioxidant properties. Molecules 2019, 24, 4570. [Google Scholar] [CrossRef] [PubMed]
- Borrego, S.; Guiamet, P.; Vivar, I.; Battiston, P. Fungal involved in biodeterioration of documents in paper and effect on substrate. Acta Microsc. 2018, 27, 37–44. [Google Scholar]
- Díaz-Alonso, J.; Bernardos, A.; Regidor-Ros, J.L.; Martínez-Manez, R.; Bosch-Roig, P. Innovative use of essential oil cold diffusion system for improving air quality on indoor cultural heritage spaces. Int. Biodet. Biodeg. 2021, 162, 105–125. [Google Scholar] [CrossRef]
- Bosco, F.; Mollea, C.; Demichela, M.; Fissore, D. Application of Essential Oils to Control the Biodeteriogenic Microorganisms in Archives and Libraries. Heritage 2022, 5, 2181–2195. [Google Scholar] [CrossRef]
- Michaelsen, A.; Pinzari, F.; Barbabietola, N.; Piñar, G. Monitoring the effects of different conservation treatments on paper-infecting fungi. Int. Biodeterior. Biodegrad. 2013, 84, 333–341. [Google Scholar] [CrossRef]
- Kwasna, H.; Karbowska-Berent, J.; Behnke-Borowczyk, J. Effect of Fungi on the Destruction of Historical Parchment and Paper Documents. Pol. J. Environ. Stud. 2020, 29, 2679–2695. [Google Scholar] [CrossRef]
- Rakotonirainy, M.S.; Lavédrine, B. Screening for antifungal activity of essential oils and related compounds to control the biocontamination in libraries and archives storage areas. Int. Biodeterior. Biodegrad. 2005, 55, 141–147. [Google Scholar] [CrossRef]
- Verticchio, E.; Frasca, F.; Bertolin, C.; Siana, A.M. Climate-induced risk for the preservation of paper collections: Comparative study among three historic libraries in Italy. Build Environ. 2021, 206, 108394. [Google Scholar] [CrossRef]
- Prakash, B.; Kedia, A.; Mishra, P.K.; Dubey, N.K. Plant essential oils as food preservatives to control moulds, mycotoxin contamination and oxidative deterioration of agri-food commodities—Potentials and challenges. Food Control 2015, 47, 381–391. [Google Scholar] [CrossRef]
- Perczak, A.; Gwiazdowska, D.; Marchwińska, K.; Juś, K.; Gwiazdowski, R.; Waśkiewicz, A. (Antifungal activity of selected essential oils against Fusarium culmorum and F. graminearum and their secondary metabolites in wheat seeds. Arch. Microbiol. 2019, 20, 1085–1097. [Google Scholar] [CrossRef]
- Alexopoulou, I.; Zervos, S. Paper conservation methods: An international survey. J. Cult. Herit. 2016, 21, 922–930. [Google Scholar] [CrossRef]
- Zervos, S.; Alexopoulou, I. Paper conservation methods: A literature review. Cellulose 2015, 22, 2859–2897. [Google Scholar] [CrossRef]
- Sequeira, S.; Cabrita, E.J.; Macedo, M.F. Antifungals on paper conservation: An overview. Int. Biodeterior. Biodegrad. 2012, 74, 67–86. [Google Scholar] [CrossRef]
- Palla, F.; Bruno, M.; Mercurio, F.; Tantillo, A.; Rotolo, V. Essential Oils as Natural Biocides in Conservation of Cultural Heritage. Molecules 2020, 25, 730. [Google Scholar] [CrossRef] [PubMed]
- Borrego, S.; Lavin, P.; Perdomo, I.; Gómez de Saravia, S.; Guiamet, P. Determination of Indoor Air Quality in Archives and Biodeterioration of the Documentary Heritage. Int. Schol. Res. Not. 2012, 2012, 680598. [Google Scholar] [CrossRef] [PubMed]
- Casiglia, S.; Bruno, M.; Scandolera, E.; Senatore, F.; Senatore, F. Influence of harvesting time on composition of the essential oil of Thymus capitatus (L.) Hoffmanns. & Link. growing wild in northern Sicily and its activity on microorganisms affecting historical art crafts. Arab. J. Chem. 2019, 12, 2704–2712. [Google Scholar]
- Moghtader, M. In vitro antifungal effects of the essential oil of Mentha piperita L. and its comparison with synthetic menthol on Aspergillus niger. Afr. J. Plant Sci. 2013, 7, 521–527. [Google Scholar] [CrossRef]
- Moghaddam, M.; Pourbaige, M.; Tabar, H.K.; Farhadi, N.; Hosseini, S.M.A. Composition and Antifungal Activity of Peppermint (Mentha piperita) Essential Oil from Iran. J. Essent. Oil-Bear. Plants 2013, 16, 506–512. [Google Scholar] [CrossRef]
- İşcan, G.; Kirimer, N.; Kürkcüoǧlu, M.; Can Başer, H.; Demirci, F. Antimicrobial Screening of Mentha piperita Essential Oils. J. Agric. Food Chem. 2002, 50, 3943–3946. [Google Scholar] [CrossRef] [PubMed]
- Hussain, A.I.; Anwar, F.; Nigam, P.S.; Ashraf, M.; Gilani, A.H. Seasonal variation in content, chemical composition and antimicrobial and cytotoxic activities of essential oils from four Mentha species. J. Sci. Food Agric. 2010, 90, 1827–1836. [Google Scholar] [CrossRef] [PubMed]
- Ali, M.M.; Yusuf, M.A.; Abdalaziz, M.N. GC-MS analysis and antimicrobial screening of essential oil from lemongrass (Cymbopogon citratus). Int. J. Pharm. Chem. 2017, 3, 72–76. [Google Scholar]
- Gao, S.; Liu, G.; Li, J.; Chen, J.; Li, L.; Zhang, X.; Zhang, S.; Thorne, R.F.; Zhang, S. Antimicrobial Activity of Lemongrass Essential Oil (Cymbopogon flexuosus) and Its Active Component Citral Against Dual-Species Biofilms of Staphylococcus aureus and Candida Species. Front. Cell. Infect. 2020, 10, 603858. [Google Scholar] [CrossRef]
- Shaaban, H.A.; Ramadan, M.M.; Amer, M.M.; El-Sideek, L.; Osman, F. Chemical composition of Cymbopogon citratus essential oil and antifungal activity against some species of mycotoxigenic Aspergillus fungi. Res. J. Appl. Sci. 2013, 9, 5770–5779. [Google Scholar]
- Degnon, R.G.; Allagbe, A.C.; Adjou, E.S.; Dahouenon-Ahoussi, E. Antifungal activities of Cymbopogon citratus essential oil against Aspergillus species isolated from fermented fish products of Southern Benin. J. Food Qual. Hazards Control 2019, 6, 53–57. [Google Scholar] [CrossRef]
- Ličina, B.Z.; Stefanović, O.D.; Vasić, S.M.; Radojević, I.D.; Dekić, M.S.; Čomić, L.R. Biological activities of the extracts from wild growing Origanum vulgare L. Food Control 2013, 33, 498–504. [Google Scholar] [CrossRef]
- Bendahou, M.; Muselli, A.; Grignon-Dubois, M.; Benyoucef, M.; Desjobert, J.-M.; Bernardini, A.-F.; Costa, J. Antimicrobial activity and chemical composition of Origanum glandulosum Desf. essential oil and extract obtained by microwave extraction: Comparison with hydrodistillation. Food Chem. 2008, 106, 132–139. [Google Scholar] [CrossRef]
- Couto, C.; Raposo, N.; Rozental, S.; Borba-Santos, L.; Bezerra, L.; De Almeida, P.; Brandão, M. Chemical Composition and Antifungal Properties of Essential Oil of Origanum vulgare Linnaeus (Lamiaceae) against Sporothrix schenckii and Sporothrix brasiliensis. Trop. J. Pharm. Res. 2015, 14, 1207. [Google Scholar] [CrossRef]
- Sim, J.H.; Jamaludin, N.S.; Khoo, C.H.; Cheah, Y.K.; Halim, S.N.B.A.; Seng, H.L.; Tiekink, E.R.T. In vitro antibacterial and time-kill evaluation of phosphanegold(I) dithiocarbamates, R3PAu[S2CN(iPr)CH2CH2OH] for R = Ph, Cy and Et, against a broad range of Gram-positive and Gram-negative bacteria. Gold Bulletin. 2014, 47, 225–236. [Google Scholar] [CrossRef]
- Stešević, D.; Jaćimović, Ž.; Šatović, Z.; Šapčanin, A.; Jančan, G.; Kosović, M.; Damjanović-Vratnica, B. Chemical characterization of wild growing Origanum vulgare populations in Montenegro. Nat. Prod. Commun. 2018, 13, 1357–1362. [Google Scholar] [CrossRef]
- Gonceariuc, M.; Balamus, Z.; Sandu, T.; Romanciuc, G.; Gonceariuc, N. Essential oil of Origanum vulgare ssp. vulgare L. and Origanum vulgare ssp. hirtum (Link) Ietswaart from Moldova: Content and chemical composition. Int. J. Agric. Innov. Res. 2014, 3, 659–663. [Google Scholar]
- Lukas, B.; Schmiderer, C.; Novak, J. Essential oil diversity of European Origanum vulgare L. (Lamiaceae). Phytochemistry 2015, 119, 32–40. [Google Scholar] [CrossRef] [PubMed]
- Mockute, D.; Bernotiene, G.; Judzentiene, A. The essential oil of Origanum vulgare L. ssp. vulgare growing wild in Vilnius district (Lithuania). Phytochemistry 2001, 57, 65–69. [Google Scholar] [CrossRef]
- Gong, H.Y.; Liu, W.H.; LV, G.Y.; Zhou, X. Analysis of essential oils of Origanum vulgare from six production areas of China and Pakistan. Rev. Bras. Farmacogn. 2014, 24, 25–32. [Google Scholar] [CrossRef]
- Vazirian, M.; Mohammadi, M.; Faraei, M.H.; Amin, G.; Amanzadeh, Y. Chemical composition and antioxidant activity of Origanum vulgare subsp. vulgare essential oil from Iran. Res. J. Pharmacogn 2015, 2, 41–46. [Google Scholar]
- Kosakowska, O.; Czupa, W. Morphological and Chemical variability of common origanum (Origanum vulgare L. subsp. vulgare) occurring in eastern Poland. Herba Pol. 2018, 64, 11–21. [Google Scholar] [CrossRef]
- Moghadam, A.R.L. Chemical composition of the essential oils of Origanum vulgare. Bull. Environ. Pharmacol. Life Sci. 2015, 4, 150–152. [Google Scholar]
- Chrishti, S.; Kaloo, Z.; Sultan, P.; Nisa, H.T.; Nisa, N.T. Quantitative analysis of the essential oil of Origanum vulgare (L) growing in the Kashmir valley. Int. J. Appl. Res. 2016, 2, 552–557. [Google Scholar]
- McKay, D.L.; Blumberg, J.B. A review of the bioactivity and potential health benefits of peppermint tea (Mentha piperita L.). Phytother. Res. 2006, 20, 619–633. [Google Scholar] [CrossRef]
- Salim, R. Carvone content and chemical composition in spearmint (Mentha spicata var. Viridis l.) as affected by herb storage under ambient temperature. J. Food Nutr. Popul. Health 2016, 1, 5. [Google Scholar]
- Buleandra, M.; Oprea, E.; Popa, D.E.; David, I.G.; Moldovan, Z.; Mihai, I.; Badea, I.A. Comparative chemical analysis of mentha piperita and m. spicata and a fast assessment of commercial peppermint teas. Nat. Prod. Commun. 2016, 11, 551–555. [Google Scholar]
- Do, D.N.; Nguyen, D.P.; Phung, V.D.; Le, X.T.; Le, T.M.; Do, V.M.; Minh, B.Q.; Luu, X.C. Fractionating of Lemongrass (Cymbopogon citratus) Essential Oil by Vacuum Fractional Distillation. Processes 2021, 9, 593. [Google Scholar] [CrossRef]
- Bossou, A.D.; Ahoussi, E.; Ruysbergh, E.; Adams, A.; Smagghe, G.; Kimpe, N.D.; Avlessi, F.; Sohounhloue, D.C.K.; Mangelinckx, S. Characterization of volatile compounds from three Cymbopogon species and Eucalyptus citrodora from Benin and their insecticidal activities against Tribolium castaneum. Ind. Crops Prod. 2015, 76, 306–317. [Google Scholar] [CrossRef]
- Hannaa, A.R.M.; Sallam, Y.I.; El-Leithy, A.S.; Aly, S.E. Lemongrass (Cymbopogon citratus) essential oil as affected by drying methods. Ann. Agric. Sci. 2012, 57, 113–116. [Google Scholar]
- Zheng, Y.; Shang, Y.; Li, M.; Li, Y.; Ouyang, W. Antifungal Activities of cis-trans Citral Isomers against Trichophyton rubrum with ERG6 as a Potential Target. Molecules 2021, 26, 4263. [Google Scholar] [CrossRef] [PubMed]
- Karadayi, M.; Yildim, V.; Güllüce, M. Antimicrobial Activity and Other Biological Properties of Oregano Essential Oil and Carvacrol. Anatol. J. Biol. 2020, 2, 52–68. [Google Scholar]
- Kamatou, G.P.P.; Vermaak, I.; Viljoen, A.M.; Lawrence, B.M. Menthol: A Simple monoterpene with remarkable biological properties. Phytochemistry 2013, 96, 15–25. [Google Scholar] [CrossRef]
- Gaonkar, R.; Avti, P.K.; Hegde, G. Differential Antifungal Efficiency of Geraniol and Citral. NPC Nat. Product Commun. 2018, 13, 1609–1614. [Google Scholar] [CrossRef]
- Skóra, J.; Gutarowska, B.; Pielech-Przybylska, K.; Stępień, L.; Pietrzak, K.; Piotrowska, M.; Pietrowski, P. Assessment of microbiological contamination in the work environments of museums, archives and libraries. Aerobiologia 2015, 31, 389–401. [Google Scholar] [CrossRef]
- Aćimović, M.; Šovljanski, O.; Pezo, L.; Travičić, V.; Tomić, A.; Zheljazkov, V.D.; Ćetković, G.; Švarc-Gajić, J.; Brezo-Borjan, T.; Sofrenić, I. Variability in biological activities of Satureja montana Subsp. montana and Subsp. variegate based on different extraction methods. Antibiotics 2022, 11, 1235. [Google Scholar] [CrossRef] [PubMed]
- Micić, D.; Đurović, S.; Riabov, P.; Tomić, A.; Šovljanski, O.; Filip, S.; Tosti, T.; Dojčinović, B.; Božović, R.; Jovanović, D.; et al. Rosemary essential oils as a promising source of bioactive compounds: Chemical composition, thermal properties, biological activity and gastronomical perspectives. Foods 2021, 10, 2734. [Google Scholar] [CrossRef]
- Aćimović, M.; Šovljanski, O.; Šeregelj, V.; Pezo, L.; Zheljazkov, V.D.; Ljujić, J.; Tomić, A.; Ćetković, G.; Čanadanović-Brunet, J.; Miljković, A.; et al. Chemical Composition, Antioxidant, and Antimicrobial Activity of Dracocephalum moldavica L. Essential Oil and Hydrolate. Plants 2022, 11, 941. [Google Scholar] [CrossRef]
- Šovljanski, O.; Tomić, A.; Pezo, L.; Ranitović, A.; Markov, S. Prediction of denitrification capacity of alkalotolerant bacterial isolates from soil—An artificial neural network model. J. Serb. Chem. Soc. 2020, 85, 1417–1427. [Google Scholar] [CrossRef]
- Šovljanski, O.; Saveljić, A.; Aćimović, M.; Šeregelj, V.; Pezo, L.; Tomić, A.; Cetković, G.; Tešević, V. Biological Profiling of Essential Oils and Hydrolates of Ocimum basilicum var. Genovese and var. Minimum Originated from Serbia. Processes 2022, 10, 1893. [Google Scholar] [CrossRef]

| Essential Oil | Fungal Strain | ||
|---|---|---|---|
| C. cladosporoides (5/1) | A. fumigatus (6/1) | P. chrysogenum (7/1) | |
| Lemongrass | 39.33 ± 1.15 | 39.00 ± 1.00 | 38.33 ± 1.53 |
| Oregano | 40.00 ± 0.00 | 40.00 ± 0.00 | 40.00 ± 0.00 |
| Rosemary | 21.33 ± 3.46 | nd * | nd |
| Peppermint | 40.00 ± 0.00 | 39.33 ± 1.15 | 40.00 ± 0.00 |
| Eucalyptus | 14.67 ± 3.21 | nd | nd |
| Actidion | 26.67 ± 0.58 | 25.67 ± 0.58 | 22.20 ± 2.00 |
| Sterile distilled water | nd | nd | nd |
| DMSO 5% | nd | nd | nd |
| Essential Oil | Fungal Strain | ||
|---|---|---|---|
| C. cladosporoides (5/1) | A. fumigatus (6/1) | P. chrysogenum (7/1) | |
| Lemongrass | 1.56 ± 0.00 * | 6.75 ± 0.00 | 6.75 ± 0.00 |
| Oregano | 0.78 ± 0.00 | 1.56 ± 0.00 | 1.56 ± 0.00 |
| Peppermint | 1.56 ± 0.00 | 6.75 ± 0.00 | 1.56 ± 0.00 |
| MIX | 0.78 ± 0.00 | 0.78 ± 0.00 | 0.78 ± 0.00 |
| Sample | Control | Oregano | Peppermint | Lemongrass | MIX |
|---|---|---|---|---|---|
| Fungal isolate | C. cladosporoides (5/1) | ||||
| d | 16.261 | 0.100 | 0.100 | 0.100 | 0.100 |
| a | 6.081 | 5.642 | 5.592 | 5.493 | 5.925 |
| c | 549.710 | 12.062 | 13.871 | 16.368 | 7.337 |
| b | 0.862 | 1.811 | 1.852 | 1.890 | 1.838 |
| A. fumigatus (6/1) | |||||
| d | 18.448 | 0.100 | 0.100 | 0.100 | 0.100 |
| a | 6.022 | 4.893 | 5.118 | 5.429 | 5.578 |
| c | 549.684 | 24.337 | 24.366 | 29.861 | 10.142 |
| b | 1.055 | 2.155 | 2.484 | 1.811 | 1.854 |
| P. chrysogenum (7/1) | |||||
| d | 18.654 | 0.100 | 0.100 | 0.100 | 0.100 |
| a | 6.178 | 6.079 | 6.081 | 6.072 | 6.159 |
| c | 549.680 | 5.685 | 6.396 | 7.452 | 4.739 |
| b | 1.092 | 2.128 | 1.830 | 1.596 | 2.047 |
| Fungi Isolate | Sample | Mathematical Model Quality Parameters | |||||||||
|---|---|---|---|---|---|---|---|---|---|---|---|
| χ2 | RMSE | MBE | MPE | r2 | Skew | Kurt | Mean | StDev | Var | ||
| C. cladosporoides (5/1) | Control | 0.006 | 0.076 | 0.002 | 0.927 | 0.988 | −0.018 | −1.33 | 0.0023 | 0.0795 | 0.006 |
| Oregano | 0.148 | 0.369 | −0.117 | 5.071 | 0.972 | 0.976 | 0.233 | −0.117 | 0.365 | 0.133 | |
| Peppermint | 0.150 | 0.371 | −0.113 | 20.223 | 0.972 | 1.074 | 0.008 | −0.113 | 0.369 | 0.136 | |
| Lemongrass | 0.152 | 0.373 | −0.103 | 20.307 | 0.971 | 1.06 | −0.011 | −0.103 | 0.374 | 0.140 | |
| MIX | 0.051 | 0.217 | −0.109 | 3.268 | 0.992 | 0.754 | −0.403 | −0.11 | 0.195 | 0.038 | |
| A. fumigatus (6/1) | Control | 0.003 | 0.057 | 0.001 | 0.642 | 0.993 | −0.180 | −0.566 | 0.001 | 0.059 | 0.003 |
| Oregano | 0.287 | 0.513 | −0.09 | 10.769 | 0.938 | 1.197 | 0.938 | −0.09 | 0.528 | 0.279 | |
| Peppermint | 0.17 | 0.396 | −0.061 | 7.400 | 0.965 | 0.86 | 1.821 | −0.061 | 0.409 | 0.167 | |
| Lemongrass | 0.304 | 0.528 | −0.146 | 11.658 | 0.949 | 0.459 | −1.533 | −0.1456 | 0.53 | 0.280 | |
| MIX | 0.109 | 0.317 | −0.112 | 7.373 | 0.979 | 0.880 | 0.409 | −0.112 | 0.309 | 0.096 | |
| P. chrysogenum (7/1) | Control | 0.001 | 0.037 | 0.000 | 0.450 | 0.997 | 0.064 | −1.202 | −0.0003 | 0.038 | 0.001 |
| Oregano | 0.029 | 0.163 | −0.103 | 0.683 | 0.998 | 0.048 | 0.926 | −0.103 | 0.132 | 0.017 | |
| Peppermint | 0.037 | 0.185 | −0.108 | 2.001 | 0.995 | 0.881 | 0.407 | −0.108 | 0.157 | 0.024 | |
| Lemongrass | 0.062 | 0.238 | −0.109 | 4.752 | 0.989 | 0.741 | −0.761 | −0.109 | 0.221 | 0.049 | |
| MIX | 0.023 | 0.144 | −0.103 | 0.754 | 0.998 | 0.0704 | 0.725 | −0.103 | 0.105 | 0.011 | |
| Essential Oil | |||||
|---|---|---|---|---|---|
| Oregano (Origanum vulgare) | Peppermint (Mentha piperita) | Lemongrass (Cymbopogon citratus) | |||
| Compounds | % | Compounds | % | Compounds | % |
| γ-terpinene | 19.6 | Menthol | 30.3 | Geranial | 51.5 |
| Carvacrol | 15.6 | Menthone | 23.8 | Neral | 36.9 |
| p-cymene | 11.0 | Menthouran | 7.5 | Myrcene | 4.8 |
| Sabinene | 8.8 | Menthyl acetate | 5.6 | Geraniol | 2.9 |
| Contaminated Area (%) * | |||||||||||||
|---|---|---|---|---|---|---|---|---|---|---|---|---|---|
| Microorganism | C. cladosporoides (5/1) | A. fumigatus (6/1) | P. chrysogenum (7/1) | ||||||||||
| Essential Oil | Oregano | Peppermint | Lemongrass | MIX | Oregano | Peppermint | Lemongrass | MIX | Oregano | Peppermint | Lemongrass | MIX | |
| Distance (cm) | 1 | 0 | 0 | 0 | 0 | 0 | 0 | 0 | 0 | 0 | 0 | 0 | 0 |
| 2.5 | 0 | 0 | 0 | 0 | 0 | 0 | 0 | 0 | 0 | 0 | 0 | 0 | |
| 3.5 | 0 | 0 | 0 | 0 | 0 | 0 | 0 | 0 | 0 | 0 | 0 | 0 | |
| 4.5 | 0 | 0 | 0 | 0 | 0 | 32 | 43 | 0 | 0 | 15 | 54 | 0 | |
| 5.5 | 0 | 0 | 0 | 0 | 32 | 53 | 61 | 0 | 11 | 91 | 92 | 0 | |
| Regression Coefficients | Microorganisms | |||||||||||
|---|---|---|---|---|---|---|---|---|---|---|---|---|
| C. cladosporoides (5/1) | A. fumigatus (6/1) | P. chrysogenum (7/1) | ||||||||||
| Essential Oil | Oregano | Peppermint | Lemongrass | MIX | Oregano | Peppermint | Lemongrass | MIX | Oregano | Peppermint | Lemongrass | MIX |
| a | - | - | - | - | 0.676 | 0.897 | 0.821 | 0 | 0.496 | 1.233 | 0.912 | - |
| b | - | - | - | - | 0.003 | 0.004 | 0.007 | 0 | 0.004 | 0.001 | 0.006 | - |
| Fungi Isolate | Sample | Mathematical Model Quality Parameters | |||||||||
|---|---|---|---|---|---|---|---|---|---|---|---|
| χ2 | RMSE | MBE | MPE | r2 | Skew | Kurt | Mean | StDev | Var | ||
| C. cladosporoides (5/1) | Oregano | - | - | - | - | - | - | - | - | - | - |
| Peppermint | - | - | - | - | - | - | - | - | - | - | |
| Lemongrass | - | - | - | - | - | - | - | - | - | - | |
| MIX | - | - | - | - | - | - | - | - | - | - | |
| A. fumigatus (6/1) | Oregano | 0.011 | 0.096 | 0.018 | 12.646 | 0.794 | 2.019 | 4.300 | 0.018 | 0.105 | 0.011 |
| Peppermint | 0.005 | 0.062 | −0.013 | 6.746 | 0.925 | 1.003 | 2.183 | −0.013 | 0.068 | 0.005 | |
| Lemongrass | 0.010 | 0.091 | −0.017 | 7.942 | 0.887 | 1.256 | 2.555 | −0.017 | 0.100 | 0.010 | |
| MIX | - | - | - | - | - | - | - | - | - | - | |
| P. chrysogenum (7/1) | Oregano | 0.001 | 0.030 | −0.005 | 9.264 | 0.721 | 1.623 | 3.118 | −0.005 | 0.033 | 0.001 |
| Peppermint | 0.005 | 0.061 | −0.035 | 14.865 | 0.985 | −0.280 | −1.523 | −0.035 | 0.055 | 0.003 | |
| Lemongrass | 0.013 | 0.103 | −0.022 | 6.539 | 0.931 | 0.952 | 2.119 | −0.022 | 0.113 | 0.013 | |
| MIX | - | - | - | - | - | - | - | - | - | - | |
| Essential Oil | Lemongrass | Oregano | Rosemary | Peppermint | Eucalyptus |
|---|---|---|---|---|---|
| Product INCI | Cymbopogon citratus leaf oil | Origanum vulgare oil | Rosmarinus officinalis leaf oil | Mentha piperita oil | Eucalyptus globulus leaf oil |
| CAS Number | 8007-02-1 | 84012-24-8 | 8000-25-7 | 84082-70-2 | 84625-32-1 |
Disclaimer/Publisher’s Note: The statements, opinions and data contained in all publications are solely those of the individual author(s) and contributor(s) and not of MDPI and/or the editor(s). MDPI and/or the editor(s) disclaim responsibility for any injury to people or property resulting from any ideas, methods, instructions or products referred to in the content. |
© 2023 by the authors. Licensee MDPI, Basel, Switzerland. This article is an open access article distributed under the terms and conditions of the Creative Commons Attribution (CC BY) license (https://creativecommons.org/licenses/by/4.0/).
Share and Cite
Tomić, A.; Šovljanski, O.; Nikolić, V.; Pezo, L.; Aćimović, M.; Cvetković, M.; Stanojev, J.; Kuzmanović, N.; Markov, S. Screening of Antifungal Activity of Essential Oils in Controlling Biocontamination of Historical Papers in Archives. Antibiotics 2023, 12, 103. https://doi.org/10.3390/antibiotics12010103
Tomić A, Šovljanski O, Nikolić V, Pezo L, Aćimović M, Cvetković M, Stanojev J, Kuzmanović N, Markov S. Screening of Antifungal Activity of Essential Oils in Controlling Biocontamination of Historical Papers in Archives. Antibiotics. 2023; 12(1):103. https://doi.org/10.3390/antibiotics12010103
Chicago/Turabian StyleTomić, Ana, Olja Šovljanski, Višnja Nikolić, Lato Pezo, Milica Aćimović, Mirjana Cvetković, Jovana Stanojev, Nebojša Kuzmanović, and Siniša Markov. 2023. "Screening of Antifungal Activity of Essential Oils in Controlling Biocontamination of Historical Papers in Archives" Antibiotics 12, no. 1: 103. https://doi.org/10.3390/antibiotics12010103
APA StyleTomić, A., Šovljanski, O., Nikolić, V., Pezo, L., Aćimović, M., Cvetković, M., Stanojev, J., Kuzmanović, N., & Markov, S. (2023). Screening of Antifungal Activity of Essential Oils in Controlling Biocontamination of Historical Papers in Archives. Antibiotics, 12(1), 103. https://doi.org/10.3390/antibiotics12010103









